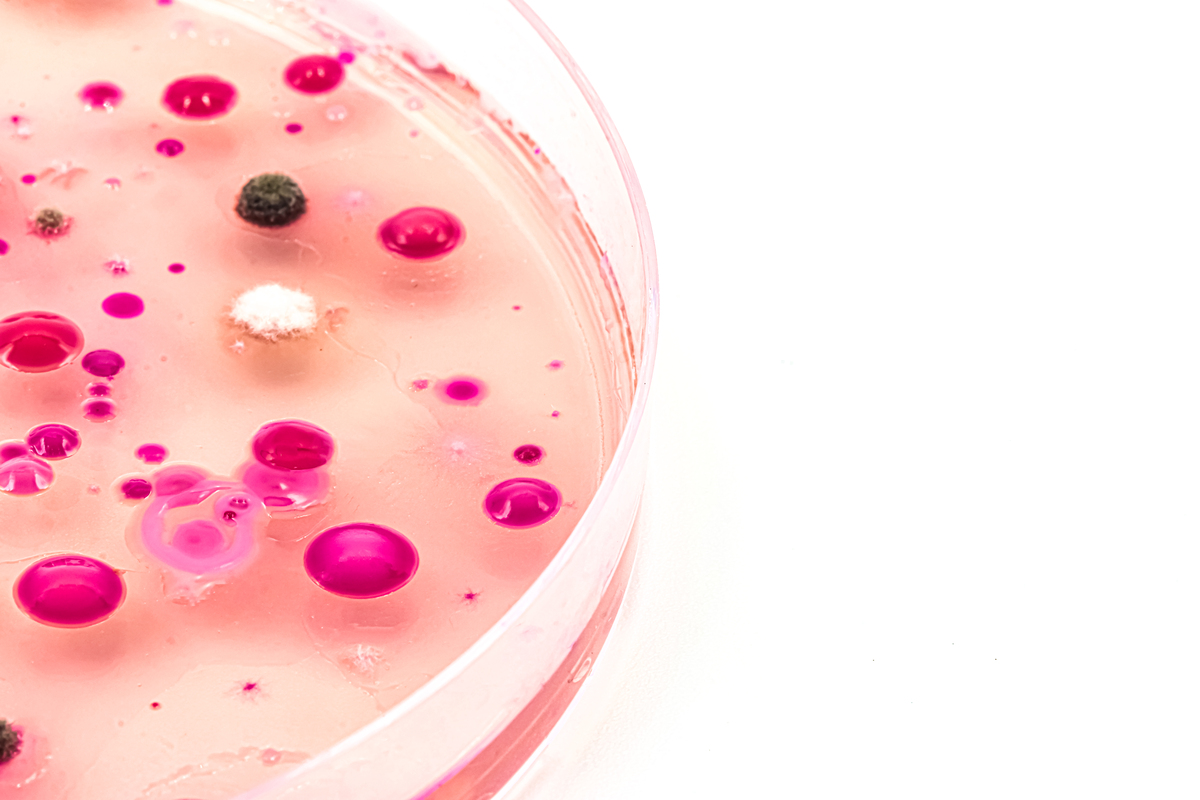
基本培养基和完全培养基的区别：如何选择合适的细菌培养基？

基本培养基和完全培养基的区别:如何选择合适的细菌培养基?
基本培养基和完全培养基是两种常见的细菌培养基,它们之间的区别主要在于其组成成分和用途不同。
基本培养基是最简单的细菌培养基,通常由水、无机盐和碳源(如葡萄糖)组成。它们可以提供细菌生长所需的基本营养物质,但不能提供所有必需的营养物质,因此只能支持某些细菌的生长。基本培养基的优点是成本低,易于制备和使用。但由于其组成简单,不能支持所有类型的细菌生长,因此在一些特殊的细菌培养中并不适用。
而完全培养基则包含了所有细菌生长所需的营养物质,包括碳源、氮源、无机盐、维生素和氨基酸等。它们可以支持各种类型的细菌生长,因此在一些特殊的细菌培养中使用较为广泛。但由于其成分复杂,制备和使用难度较大,成本也相对较高。
总之,基本培养基和完全培养基在组成、用途和优缺点等方面存在差异。在实际应用中,应根据需要选择合适的培养基。
原文地址: https://www.cveoy.top/t/topic/lvW7 著作权归作者所有。请勿转载和采集!